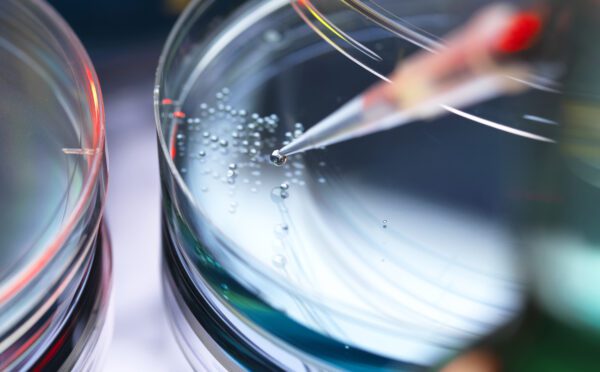
Six Osler lawyers recognized by Who’s Who Legal Life Sciences — Canada

The pharmaceutical, biotech and life sciences sectors are key contributors to Canada’s economy, developing products and services that improve the quality of life for all Canadians.
The rapid development and adoption of virtual medicine is disrupting how people are cared for and how companies in the sector do business. The shift from treatment of disease to prevention, diagnostics and cure is attracting a host of exciting new entrants from both the traditional pharmaceutical, biotech and life sciences fields and from new players. As development occurs, the various industries in this ecosystem recognize the need to protect what they have created — the intellectual property rights of new inventions and processes.
Keeping pace with the fast-moving nature of these sectors also means managing the complex risks inherent in the existing commercial and regulatory environment.
How we can help
At Osler, our firm has been modelled to address client needs at every stage. Our top-ranked Intellectual Property team is respected for its diverse strengths, including excellence in IP litigation, particularly our leading patent litigation practice, and for securing intellectual property rights through prosecution, licensing, and strategic portfolio advice.
Osler acts as an essential business partner by developing and executing global intellectual property strategies in prosecution and litigation that align with our clients’ objectives. Our firm has a substantial presence in pharmaceutical-related litigation and dispute resolution, in particular patent and class action. Local and international clients from a broad range of industries retain Osler for our leading IP prosecution services before every level of the Canadian courts, as well as before international tribunals.
Our firm routinely acts as counsel to the world’s largest and leading generic pharmaceutical companies. Strategically situated in the major English and French-speaking R&D hubs of Toronto, Montréal, Vancouver and Ottawa, our lawyers help guide investors, emerging and established companies, and research organizations through all stages of growth.
Osler also represents many clients on the buy-side in this sector, including private equity groups, venture capital funds, angel investors and investment banks focused on this area of business. In addition to working with Canadian funds, our team advises various U.S. funds on their Canadian investing and exit transactions.
Our lawyers further bring expertise in corporate law, mergers and acquisitions, private and public financing transactions, fund formation, collaborations, technology transfer, licensing and regulatory matters. Our life sciences group members hold relevant degrees in experimental medicine, biochemistry, pharmacy, veterinary medicine, pharmacology and epidemiology.
Key Contacts
Partner, Emerging and High Growth Companies, Montréal
Partner, Intellectual Property, Toronto
Ottawa Managing Partner, Ottawa
Latest Insights
-
Report December 5, 2024
The devil is in the details: legislative changes and access to healthcare
Legislative amendments are initiating significant developments in health reform.
Read more -
Osler Update September 16, 2024
Curb your (lobbying) enthusiasm? Navigating Canada’s lobbying regulations – insights for the pharmaceutical industry
The interplay of legal frameworks, ethical considerations and diverse stakeholders make lobbying a complex and sensitive process.
Read more -
Osler Update October 17, 2023
It ended before it began: first private party sought leave to bring an ‘abuse of dominance’ application under the Competition Act
Just two weeks after applying for leave to the Competition Tribunal seeking a remedial order under the Competition Act “abuse of dominance”...
Read more -
Osler Update February 23, 2023
Ontario proposes new legislation for private health facilities and surgical centres
On February 21, 2023, the Ontario government tabled Bill 60, Your Health Act, 2023 (Bill 60), following its recent announcement of its plan to reduce...
Read more
Stay up to date with our latest insights
SubscribeAwards and Recognition
-
Recognized in Life Sciences, Intellectual Property and IP Litigation.
—Chambers Canada: Canada’s Leading Lawyers for Business -
Osler lawyers recognized in Life Sciences.
—Who’s Who Legal
Osler, Hoskin & Harcourt is a great team without exception.
In the Media
-
Osler News July 2, 2025
Osler lawyers recognized in Lexpert Special Edition: Health Sciences 2025
Osler is proud to announce that 10 of our lawyers are recognized in the Lexpert Special Edition: Health Sciences 2025. This prestigious...
Read more -
Media Mentions June 17, 2024
Health law lawyers advising clients on legal requirements arising from virtual care, AI, big data — Lexpert
Like most sectors right now, healthcare is facing its own unique challenges when it comes to the adoption of artificial intelligence. In a Lexpert...
Read more -
Osler News April 22, 2024
Six Osler lawyers recognized by Who’s Who Legal Life Sciences — Canada
Osler congratulations the six members of the firm who have earned the “Recommended” rating from Who’s Who Legal (WWL) Life Sciences — Canada.
Read more -
Media Mentions October 13, 2023
Alberta’s Booming Tech Sector: The Making of Canada’s Silicon Valley – This Professional Life
The growth and success of the tech sector in Alberta is helping drive the diversification of the economy.
Read more